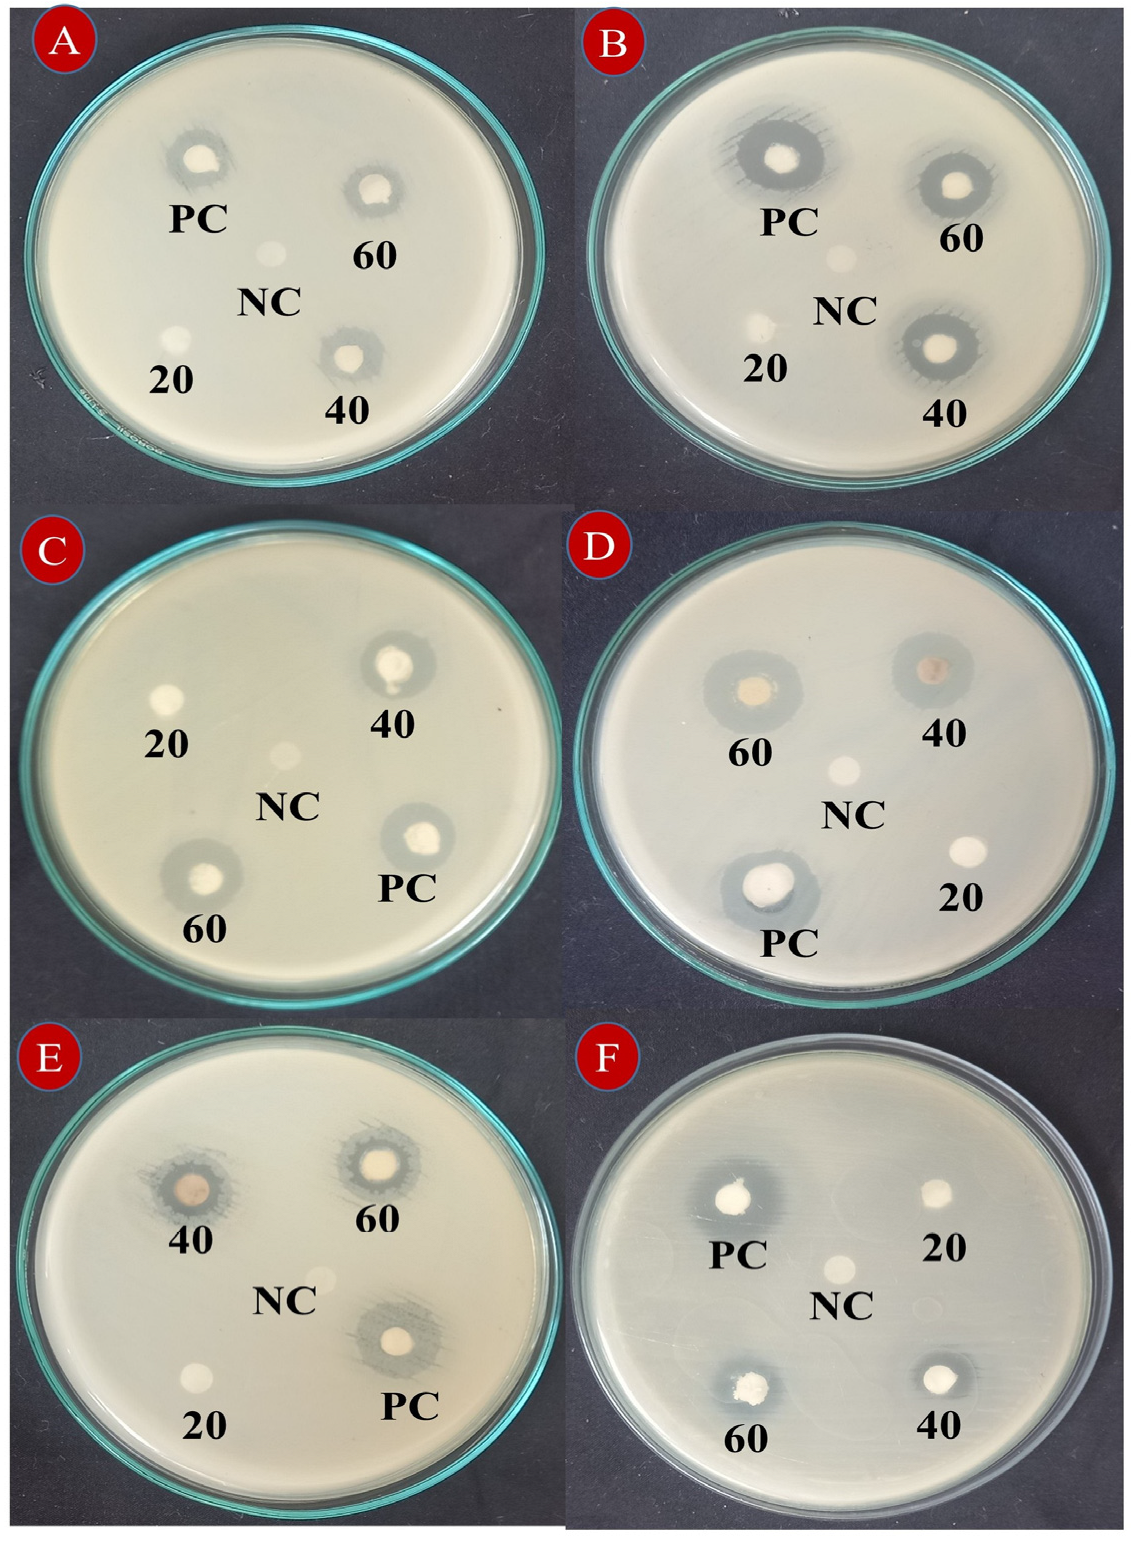
Nanomaterials 15 00084 g007

Eco-Friendly Synthesis of Zirconium Dioxide Nanoparticles from Toddalia asiatica: Applications in Dye Degradation, Antioxidant and Antibacterial Activity
Abstract
:1. Introduction
2. Materials and Methods
2.1. Chemicals and Reagents
2.2. Plant Collection and Extract Preparation
2.3. Synthesis of ZrO2 NPs
2.4. Characterization of ZrO2 NPs
2.5. Photocatalytic Dye Degradation Study
2.6. Antibacterial Activity Test
2.7. Antioxidant Activity Test
2.8. Statistical Analysis
3. Results and Discussion
3.1. XRD Pattern Analysis
3.2. UV–Visible Absorption Spectrum
3.3. Particle Size Analysis
3.4. FTIR Analysis
3.5. SEM-EDAX Analysis
3.6. TEM Analysis
3.7. Photocatalytic Dye Degradation Activity
3.8. Antibacterial Activity
3.9. Antioxidant Activities
4. Conclusions
Author Contributions
Funding
Data Availability Statement
Conflicts of Interest
References
- Nguyen, T.D. From formation mechanisms to synthetic methods toward shape-controlled oxide nanoparticles. Nanoscale 2013, 5, 9455. [Google Scholar] [CrossRef] [PubMed]
- Rimer, J.D.; Chawla, A.; Le, T.T. Crystal engineering for catalysis. Annu. Rev. Chem. Biomol. Eng. 2018, 9, 283–309. [Google Scholar] [CrossRef] [PubMed]
- Narayanan, M.; Deepika, M.; Ma, Y.; Nasif, O.; Alharbi, S.A.; Srinivasan, R.; Natarajan, D. Phyto-fabrication, characterization, and biomedical activity of silver nanoparticles mediated from an epiphytic plant Luisia tenuifolia blume. Appl. Nanosci. 2021, 13, 3347–3357. [Google Scholar] [CrossRef]
- George, J.M.; Antony, A.; Mathew, B. Metal oxide nanoparticles in electrochemical sensing and biosensing: A review. Microchim. Acta 2018, 185, 358. [Google Scholar] [CrossRef]
- Chitoria, A.K.; Mir, A.; Shah, M.A. A review of ZrO2 nanoparticles applications and recent advancements. Ceram. Int. 2023, 49, 32343–32358. [Google Scholar] [CrossRef]
- Karthikeyan, C.; Arunachalam, P.; Ramachandran, K.; Al-Mayouf, A.M.; Karuppuchamy, S. Recent advances in semiconductor metal oxides with enhanced methods for solar photocatalytic applications. J. Alloys Compds. 2020, 828, 154281. [Google Scholar] [CrossRef]
- Gurushantha, K.; Anantharaju, K.S.; Nagabhushana, H.; Sharma, S.C.; Vidya, Y.S.; Shivakumara, C.; Nagaswarupa, H.P.; Prashantha, S.C.; Anilkumar, M.R. Facile green fabrication of iron-doped cubic ZrO2 nanoparticles by Phyllanthus acidus: Structural, photocatalytic and photoluminescent properties. J. Mol. Catal. A Chem. 2015, 397, 36–47. [Google Scholar] [CrossRef]
- Renuka, L.; Anantharaju, K.S.; Sharma, S.C.; Nagaswarupa, H.P.; Prashantha, S.C.; Nagabhushana, H.; Vidya, Y.S. Hollow microspheres Mg doped ZrO2 nanoparticles: Green assisted synthesis and applications in photocatalysis and photoluminescence. J. Alloys Compd. 2016, 672, 609–622. [Google Scholar] [CrossRef]
- Jadoun, S.; Arif, R.; Jangid, N.K.; Meena, R.K. Green synthesis of nanoparticles using plant extracts: A review. Environ. Chem. Lett. 2021, 19, 355–374. [Google Scholar] [CrossRef]
- Indhira, D.; Manikandan, K.; Ameen, F.; Bhat, S.A.; Kathirvel, A.; Srinivasan, R.; Ranjith Priyan, S.; Suresh Kumar, G. Biomimetic facile synthesis of zinc oxide and copper oxide nanoparticles from Elaeagnus indica for enhanced photocatalytic activity. Environ. Res. 2022, 212, 113323. [Google Scholar] [CrossRef]
- Shrimal, P.; Jadeja, G.; Patel, S. A review on novel methodologies for drug nanoparticle preparation: Microfluidic approach. Chem. Eng. Res. Des. 2020, 153, 728–756. [Google Scholar] [CrossRef]
- Agalya, P.; Suresh Kumar, G.; Prabu, K.M.; Cholan, S.; Karunakaran, G.; Hakami, J.; Shkir, M.; Ramalingam, S. One-pot ultrasonic-assisted synthesis of magnetic hydroxyapatite nanoparticles using mussel shell biowaste with the aid of trisodium citrate. Ceram. Int. 2022, 48, 28299–28307. [Google Scholar] [CrossRef]
- Rana, A.; Yadav, K.; Jagadevan, S. A comprehensive review on green synthesis of nature-inspired metal nanoparticles: Mechanism, application and toxicity. J. Clean. Prod. 2020, 272, 122880. [Google Scholar] [CrossRef]
- Bokov, D.; Jalil, A.T.; Chupradit, A.; Suksatan, W.; Ansari, M.J.; Shewael, I.H.; Valiev, G.H.; Kianfar, E. Nanomaterial by sol-gel method: Synthesis and application. Adv. Mater. Sci. Eng. 2021, 2021, 5102014. [Google Scholar] [CrossRef]
- Abou-Gamra, Z.M.; Ahmed, M.A. Synthesis of mesoporous TiO2 curcumin nanoparticles for photocatalytic degradation of methylene blue dye. J. Photochem. Photobiol. B Biol. 2016, 160, 134–141. [Google Scholar] [CrossRef]
- Anbukkarasi, V.; Srinivasan, R.; Elangovan, N. Antimicrobial activity of green synthesized zinc oxide nanoparticles from Emblica Officinalis. Int. J. Pharm. Sci. Rev. Res. 2015, 33, 110–115. [Google Scholar]
- Vijayaraghavan, K.; Ashokkumar, T. Plant mediated biosynthesis of metallic nanoparticles: A review of literature, factors affecting synthesis, characterization techniques and applications. J. Environ. Chem. Eng. 2017, 5, 4866–4883. [Google Scholar] [CrossRef]
- Shafey, A.M.E. Green synthesis of metal and metal oxide nanoparticles from plant leaf extracts and their applications: A review. Green Process. Syn. 2020, 9, 304–339. [Google Scholar] [CrossRef]
- Manjula, R.; Thenmozhi, M.; Thilagavathi, S.; Srinivasan, R.; Kathirvel, A. Green synthesis and characterization of manganese oxide nanoparticles from Gardenia resinifera leaves. Mater. Today Proc. 2019, 26, 3559–3563. [Google Scholar] [CrossRef]
- Zhang, X.; Sun, W.; Yang, Z.; Liang, Y.; Zhou, W.; Tang, L. Hemostatic chemical constituents from natural medicine Toddalia asiatica root bark by LC-ESI Q-TOF MSE. Chem. Cent. J. 2017, 11, 55. [Google Scholar] [CrossRef]
- Murugan, K.; Venus, J.S.; Panneerselvam, C.; Bedini, S.; Conti, B.; Nicoletti, M.; Sarkar, S.K.; Hwang, J.S.; Subramaniam, J.; Madhiyazhagan, P.; et al. Biosynthesis, mosquitocidal and antibacterial properties of Toddalia asiatica synthesized silver nanoparticles: Do they impact predation of guppy Poecilia reticulata against the filariasis mosquito Culex quinquefasciatus? Environ. Sci. Pollut. Res. 2015, 22, 17053–17064. [Google Scholar] [CrossRef]
- Kaveri, R.; Kalaivani, K. Characterization of silver nanoparticles using leaf extract of medicinally potent plant Toddalia asiatica (L.) Lam. World J. Pharm. Pharm. Sci. 2020, 9, 807–820. [Google Scholar]
- Thangavelu, K.; Ravisankar, N.; Siddiq, A.; Joseph, J. In vitro antioxidant and anticancer potential of flowers of Toddalia asiatica (Rutaceae). Int. J. Pharm. Pharm. Sci. 2015, 7, 95–99. [Google Scholar]
- Duraipandiyan, V.; Ignacimuthu, S. Antibacterial and antifungal activity of flindersine isolated from the traditional medicinal plant Toddalia asiatica (L.) Lam. J. Ethnopharmacol. 2009, 123, 494–498. [Google Scholar] [CrossRef] [PubMed]
- Irudayaraj, S.S.; Jincy, J.; Sunil, C.; Duraipandiyan, V.; Ignacimuthu, S.; Chandramohan, G.; Maria Packiam, S. Antidiabetic with antilipidemic and antioxidant effects of flindersine by enhanced glucose uptake through GLUT4 translocation and PPARγ agonism in type 2 diabetic rats. J. Ethnopharmacol. 2022, 285, 114883. [Google Scholar] [CrossRef]
- Oketch-Rabah, H.A.; Mwangi, J.W.; Lisgarten, J.; Mberu, E.K. A new antiplasmodial coumarin from Toddalia asiatica roots. Fitoterapia 2000, 71, 636–640. [Google Scholar] [CrossRef] [PubMed]
- Lu, S.Y.; Qiao, Y.-J.; Xiao, P.-G.; Tan, X.-H. Identification of antiviral activity of Toddalia asiatica against influenza type A virus. China J. Chin. Mater. Medica 2005, 30, 998–1001. [Google Scholar]
- Indhira, D.; Aruna, A.; Manikandan, K.; Albeshr, M.F.; Alrefaei, A.F.; Vinayagam, R.; Kathirvel, A.; Priyan, S.R.; Kumar, G.S.; Srinivasan, R. Antimicrobial and photocatalytic activities of selenium nanoparticles synthesized from Elaeagnus indica leaf extract. Processes 2023, 11, 1107. [Google Scholar] [CrossRef]
- Srinivasan, R.; Aruna, A.; Manigandan, K.; Pugazhendhi, A.; Kim, M.; Shivakumar, M.S.; Natarajan, D. Phytochemical, antioxidant, antimicrobial and antiproliferative potential of Elaeagnus indica. Biocatal. Agric. Biotechnol. 2019, 20, 101265. [Google Scholar] [CrossRef]
- Bandeira, M.; Giovanela, M.; Roesch-Ely, M.; Devine, D.M.; Silva Crespo, J.D. Green synthesis of zinc oxide nanoparticles: A review of the synthesis methodology and mechanism of formation. Sustain. Chem. Pharm. 2020, 15, 100223. [Google Scholar] [CrossRef]
- Sujatha, V.; Kathirvel, A.; Prakash, S.; Balasubramaniyan, M. Phytochemical and antioxidant properties of Anemia wightiana leaf extracts. Ind. Chem. Soc. 2015, 92, 891–894. [Google Scholar]
- Kathirvel, A.; Sujatha, V. Phytochemical studies, antioxidant activities and identification of active compounds using GC-MS of Dryopteris cochleata leaves. Arab. J. Chem. 2016, 9, S1435–S1442. [Google Scholar] [CrossRef]
- Goyal, P.; Bhardwaj, A.; Mehta, B.K.; Mehta, D. Green synthesis of zirconium oxide nanoparticles (ZrO2 NPs) using Helianthus annuus seed and their antimicrobial effects. J. Indian Chem. Soc. 2021, 98, 100089. [Google Scholar] [CrossRef]
- Nikam, A.; Pagar, T.; Ghotekar, S.; Pagar, K.; Pansambal, S. A review on plant extract mediated green synthesis of zirconia nanoparticles and their miscellaneous, applications. J. Chem. Rev. 2019, 1, 154–163. [Google Scholar]
- Tran, T.V.; Nguyen, D.T.C.; Kumar, P.S.; Din, A.T.M.; Jalil, A.A.; Vo, D.V.N. Green synthesis of ZrO2 nanoparticles and nanocomposites for biomedical and environmental applications: A review. Environ. Chem. Lett. 2022, 20, 1309–1331. [Google Scholar] [CrossRef]
- Sahani, R.; Jaybhaye, S. Biosynthesis of zirconia (ZrO2) nanoparticles using plant extract: A review. Int. J. Creat. Res. Thoughts 2023, 11, 6–14. [Google Scholar]
- Chelliah, P.; Wabaidur, S.M.; Sharma, H.P.; Majdi, H.S.; Smait, D.A.; Najm, M.A.; Iqbal, A.; Lai, W.C. Photocatalytic organic contaminant degradation of green synthesized ZrO2 NPs and their antibacterial activities. Separations 2023, 10, 156. [Google Scholar] [CrossRef]
- Selvam, K.; Sudhakar, C.; Selvankumar, T.; Senthilkumar, B.; Kim, W.; Al-Ansari, M.M.; Al-Humaid, L. Photocatalytic degradation of malachite green and antibacterial potential of biomimetic synthesized zirconium oxide nanoparticles using Annona reticulata leaf extract. Appl. Nanosci. 2023, 13, 2837–2843. [Google Scholar] [CrossRef]
- Shinde, H.M.; Bhosale, T.T.; Gavade, N.L.; Babar, S.B.; Kamble, R.J.; Shirke, B.S.; Garadkar, K.M. Biosynthesis of ZrO2 nanoparticles from Ficus benghalensis leaf extract for photocatalytic activity. J. Mater. Sci. Mater. Electron. 2018, 29, 14055–14064. [Google Scholar] [CrossRef]
- Yuan, Y.; Wu, Y.; Suganthy, N.; Shanmugam, S.; Brindhadevi, K.; Sabour, A.; Alshiekheid, M.; Lan Chi, N.T.; Pugazhendhi, A.; Shanmuganathan, R. Biosynthesis of zirconium nanoparticles (ZrO2 NPs) by Phyllanthus niruri extract: Characterization and its photocatalytic dye degradation activity. Food Chem. Toxicol. 2022, 168, 113340. [Google Scholar] [CrossRef]
- Pronin, I.A.; Averin, I.A.; Karmanov, A.A.; Yakushova, N.D.; Komolov, A.S.; Lazneva, E.F.; Sychev, M.M.; Moshnikov, V.A.; Korotcenkov, G. Control over the surface properties of zinc oxide powders via combining mechanical, electron beam, and thermal processing. Nanomaterials. 2022, 12, 1924. [Google Scholar] [CrossRef] [PubMed]
- Komolov, A.S.; Lazneva, E.F.; Gerasimova, N.B.; Panina, Y.A.; Sobolev, V.S.; Koroleva, A.V.; Pshenichnyuk, S.A.; Asfandiarov, N.L.; Modelli, A.; Handke, B.; et al. Conduction band electronic states of ultrathin layers of thiophene/phenylene co-oligomers on an oxidized silicon surface. J. Electron Spectrosc. Relat. Phenom. 2019, 235, 40–45. [Google Scholar] [CrossRef]
- Maridurai, T.; Balaji, D.; Sagadevan, S. Synthesis and characterization of yttrium stabilized zirconia nanoparticles. Mater. Res. 2016, 19, 812–816. [Google Scholar] [CrossRef]
- Hasan, I.M.A.; Salah El-Din, H.; AbdElRaady, A.A. Peppermint mediated green synthesis of nano ZrO2 and Its adsorptive removal of cobalt from water. Inorganics 2022, 10, 257. [Google Scholar] [CrossRef]
- Jeyasakthy, S.; Premaratne, W.A.P.J. Green synthesis and characterization of zirconia nanoparticles using Averrhoa bilimbi. In Proceedings of the International Postgraduate Research Conference, Faculty of Graduate Studies, University of Kelaniya, Kelaniya, Sri Lanka, 30 December 2019; p. 95. [Google Scholar]
- Davar, F.; Majedi, A.; Mirzaei, A. Polyvinyl alcohol thin film reinforced by green synthesized zirconia nanoparticles. Ceram. Int. 2018, 44, 19377–19382. [Google Scholar] [CrossRef]
- Kumaresan, M.; Vijai Anand, K.; Govindaraju, K.; Tamilselvan, S.; Ganesh Kumar, V. Seaweed Sargassum wightii mediated preparation of zirconia (ZrO2) nanoparticles and their antibacterial activity against gram positive and gram negative bacteria. Microb. Pathog. 2018, 124, 311–315. [Google Scholar] [CrossRef]
- Al-Zaqri, N.; Muthuvel, A.; Jothibas, M.; Alsalme, A.; Alharthi, F.A.; Mohana, V. Biosynthesis of zirconium oxide nanoparticles using Wrightia tinctoria leaf extract: Characterization, photocatalytic degradation and antibacterial activities. Inorg. Chem. Commun. 2021, 127, 108507. [Google Scholar] [CrossRef]
- Sudrajat, H.; Babel, S.; Sakai, H.; Takizawa, S. Rapid enhanced photocatalytic degradation of dyes using novel N-doped ZrO2. J. Environ. Manag. 2016, 165, 224–234. [Google Scholar] [CrossRef]
- Agorku, E.S.; Kuvarega, A.T.; Mamba, B.B.; Pandey, A.C.; Mishra, A.K. Enhanced visible-light photocatalytic activity of multi-elements-doped ZrO2 for degradation of indigo carmine. J. Rare Earths 2015, 33, 498–506. [Google Scholar] [CrossRef]
- Hanafi, H.W.; Sapawe, N. Nd doped ZrO2 photocatalyst for organic pollutants degradation in wastewater. Mater. Today Proc. 2019, 19, 1524–1528. [Google Scholar]
- Khataee, A.; Kayan, B.; Gholami, P.; Kalderis, D.; Akay, S.; Dinpazhoh, L. Sonocatalytic degradation of reactive yellow 39 using synthesized ZrO2 nanoparticles on biochar. Ultrason. Sonochem. 2017, 39, 540–549. [Google Scholar] [CrossRef] [PubMed]
- Reddy, C.; Babu, B. Synthesis and characterization of pure tetragonal ZrO2 nanoparticles with enhanced photocatalytic activity. Ceram. Int. 2018, 44, 6940–6948. [Google Scholar] [CrossRef]
- Vinayagam, R.; Singhania, B.; Murugesan, G.; Senthil Kumar, P.; Bhole, R.; Narasimhan, M.; Varadavenkatesan, T.; Selvaraj, R. Photocatalytic degradation of methylene blue dye using newly synthesized zirconia nanoparticles. Environ. Res. 2022, 214, 113785. [Google Scholar] [CrossRef]
- Dharr, A.; Arjun, A.; Raguram, T.; Rajni, K.S. Influence of pH on the structural, spectral, optical, morphological and photocatalytic properties of ZrO2 nanoparticles synthesized by sol–gel technique. J. Mater. Sci. Mater. Electron. 2020, 31, 15718–15730. [Google Scholar] [CrossRef]
- Karthik, K.; Madhukara Naik, M.; Shashank, M.; Vinuth, M.; Revathi, V. Microwave assisted ZrO2 NPs and its photocatalytic and antibacterial studies. J. Clust. Sci. 2019, 30, 311–318. [Google Scholar] [CrossRef]
- Basahel, S.N.; Ali, T.T.; Mokhtar, M.; Narasimharao, K. Influence of crystal structure of nanosized ZrO2 on photocatalytic degradation of methyl orange. Nanoscale Res. Lett. 2015, 10, 73. [Google Scholar] [CrossRef]
- Sreethawong, T.; Ngamsinlapasathian, S.; Yoshikawa, S. Synthesis of crystalline mesoporous assembled ZrO2 nanoparticles via a facile surfactant-aided sol–gel process and their photocatalytic dye degradation activity. Chem. Eng. J. 2013, 228, 256–262. [Google Scholar] [CrossRef]
- Tayeb, A.M.; Hussein, D.S. Synthesis of TiO2 nanoparticles and their photocatalytic activity for methylene blue. Am. J. Nanomater. 2015, 3, 57–63. [Google Scholar]
- Modi, S.K.; Nehra, M.; Kumar, S.; Mange, P.L.; Modi, K.B.; Dubey, S. Synthesis characterization and performance of zirconia nanoparticulates as an antibacterial antifungal and anticancer activity agent. BioNanoScience 2024, 14, 2529–2540. [Google Scholar] [CrossRef]
- Amornpitoksuk, P.; Suwanboon, S.; Sangkanu, S.; Sukhoom, A.; Wudtipan, J.; Srijan, K.; Kaewtaro, S. Synthesis, photocatalytic and antibacterial activities of ZnO particles modified by diblock copolymer. Powder Technol. 2011, 212, 432–438. [Google Scholar] [CrossRef]
- Salar, R.K.; Sharma, P.; Kumar, N. Enhanced antibacterial activity of streptomycin against some human pathogens using green synthesized silver nanoparticles. Resour. Effic. Technol. 2015, 1, 106–115. [Google Scholar]
- Agarwal, H.; Menon, S.; Kumar, S.V.; Rajeshkumar, S. Mechanistic study on antibacterial action of zinc oxide nanoparticles synthesized using green route. Chem. Biol. Interact. 2018, 286, 60–70. [Google Scholar] [CrossRef] [PubMed]
- Qidwai, A.; Pandey, A.; Kumar, R.; Shukla, S.K.; Dikshit, A. Advances in biogenic nanoparticles and the mechanisms of antimicrobial effects. Ind. J. Pharm. Sci. 2018, 80, 592–603. [Google Scholar] [CrossRef]
- Gowri, S.; Gandhi, R.R.; Sundrarajan, M. Structural, optical, antibacterial and antifungal properties of zirconia nanoparticles by biobased protocol. J. Mater. Sci. Technol. 2014, 30, 782–790. [Google Scholar] [CrossRef]
- Annu, A.; Sivasankari, C.; Krupasankar, U. Synthesis and characterization of ZrO2 nanoparticle by leaf extract bioreduction process for its biological studies. Mater. Today Proc. 2020, 33, 5317–5323. [Google Scholar] [CrossRef]
- Li, Z.; Ma, J.; Ruan, J.; Zhuang, X. Using positively charged magnetic nanoparticles to capture bacteria at ultralow concentration. Nanoscale Res. Lett. 2019, 14, 195. [Google Scholar] [CrossRef]
- Xing, X.; Ma, W.; Zhao, X.; Wang, J.; Yao, L.; Jiang, X.; Wu, Z. Interaction between surface charge modified gold nanoparticles and phospholipid membranes. Langmuir 2018, 34, 12583–12589. [Google Scholar] [CrossRef]
- Akintelu, S.A.; Folorunso, A.S. A review on green synthesis of zinc oxide nanoparticles using plant extracts and its biomedical applications. BioNanoScience 2020, 10, 848–863. [Google Scholar] [CrossRef]
- Slavin, Y.N.; Asnis, J.; Häfeli, U.O.; Bach, H. Metal nanoparticles: Understanding the mechanisms behind antibacterial activity. J. Nanobiotech. 2017, 15, 65. [Google Scholar] [CrossRef]
- Nguyen, D.T.C.; Nguyen, T.T.; Le, H.T.N.; Nguyen, T.T.T.; Bach, L.G.; Nguyen, T.D.; Vo, D.V.N.; Van Tran, T. The sunflower plant family for bioenergy, environmental remediation, nanotechnology, medicine, food and agriculture: A Review. Environ. Chem. Lett. 2021, 19, 3701–3726. [Google Scholar] [CrossRef]
- Balaji, S.; Mandal, B.K.; Ranjan, S.; Dasgupta, N.; Chidambaram, R. Nano-zirconia evaluation of its antioxidant and anticancer activity. J. Photochem. Photobiol. B Biol. 2017, 170, 125–133. [Google Scholar] [CrossRef] [PubMed]
- Ramalingam, S.; Kob, Y.K.; Lee, J.S.; Bahuguna, A.; Kim, M. Effects of the fruit maturity, processing method and fermentation time on the physicochemical, functional and microbial properties of Prunus mume (maesil) sugar syrup during a 1-year fermentation period. LWT Food Sci. Technol. 2022, 159, 113174. [Google Scholar] [CrossRef]
- Del Caro, A.; Piga, A.; Pinna, I.; Fenu, P.M.; Agabbio, M. Effect of drying conditions and storage period on polyphenolic content, antioxidant capacity, and ascorbic acid of prunes. J. Agric. Food Chem. 2004, 52, 4780–4784. [Google Scholar] [CrossRef] [PubMed]
- Khan, I.T.; Nadeem, M.; Imran, M.; Ullah, R.; Ajmal, M.; Jaspal, M.H. Antioxidant properties of Milk and dairy products: A comprehensive review of the current knowledge. Lipids Health Dis. 2019, 18, 41. [Google Scholar] [CrossRef]

| ZrO2 NPs Dose (µg) | Diameter of Zone of Inhibition (in mm) | |||||
|---|---|---|---|---|---|---|
| B. subtilis | S. aureus | S. epidermidis | K. pneumoniae | P. vulgaries | E. coli | |
| 20 | 02.33 ± 0.58 b | 00.67 ± 0.58 a | 02.67 ± 0.58 b | 02.67 ± 0.58 b | 01.67 ± 0.58 b | 02.67 ± 0.58 b |
| 40 | 10.33 ± 0.58 c | 10.67 ± 0.58 b | 09.00 ± 1.00 c | 14.67 ± 0.58 c | 14.33 ± 0.58 c | 10.67 ± 0.58 c |
| 60 | 12.00 ± 1.00 c | 12.33 ± 0.58 c,b | 14.00 ± 1.00 d | 17.33 ± 0.58 d | 17.67 ± 0.58 d | 20.67 ± 0.58 d |
| PC * | 17.33 ± 1.15 d | 14.67 ± 0.58 d | 19.67 ± 0.58 e | 18.67 ± 0.58 d | 19.67 ± 0.58 e | 25.00 ± 1.00 e |
| NC * | 00.00 ± 0.00 a | 00.00 ± 0.00 a | 00.00 ± 0.00 a | 00.00 ± 0.00 a | 00.00 ± 0.00 a | 00.00 ± 0.00 a |
Disclaimer/Publisher’s Note: The statements, opinions and data contained in all publications are solely those of the individual author(s) and contributor(s) and not of MDPI and/or the editor(s). MDPI and/or the editor(s) disclaim responsibility for any injury to people or property resulting from any ideas, methods, instructions or products referred to in the content. |
© 2025 by the authors. Licensee MDPI, Basel, Switzerland. This article is an open access article distributed under the terms and conditions of the Creative Commons Attribution (CC BY) license (https://creativecommons.org/licenses/by/4.0/).
Share and Cite
Kathirvel, A.; Srinivasan, R.; Harini, S.; Ranjith, N.; Kumar, G.S.; Lalithambigai, K.; Atchudan, R.; Habila, M.A.; Aljuwayid, A.M.; Yun, H.K. Eco-Friendly Synthesis of Zirconium Dioxide Nanoparticles from Toddalia asiatica: Applications in Dye Degradation, Antioxidant and Antibacterial Activity. Nanomaterials 2025, 15, 84. https://doi.org/10.3390/nano15020084
Kathirvel A, Srinivasan R, Harini S, Ranjith N, Kumar GS, Lalithambigai K, Atchudan R, Habila MA, Aljuwayid AM, Yun HK. Eco-Friendly Synthesis of Zirconium Dioxide Nanoparticles from Toddalia asiatica: Applications in Dye Degradation, Antioxidant and Antibacterial Activity. Nanomaterials. 2025; 15(2):84. https://doi.org/10.3390/nano15020084
Chicago/Turabian StyleKathirvel, Arumugam, Ramalingam Srinivasan, Sathasivam Harini, Natarajan Ranjith, Govindan Suresh Kumar, Kesavan Lalithambigai, Raji Atchudan, Mohamed A. Habila, Ahmed M. Aljuwayid, and Hae Keun Yun. 2025. "Eco-Friendly Synthesis of Zirconium Dioxide Nanoparticles from Toddalia asiatica: Applications in Dye Degradation, Antioxidant and Antibacterial Activity" Nanomaterials 15, no. 2: 84. https://doi.org/10.3390/nano15020084
APA StyleKathirvel, A., Srinivasan, R., Harini, S., Ranjith, N., Kumar, G. S., Lalithambigai, K., Atchudan, R., Habila, M. A., Aljuwayid, A. M., & Yun, H. K. (2025). Eco-Friendly Synthesis of Zirconium Dioxide Nanoparticles from Toddalia asiatica: Applications in Dye Degradation, Antioxidant and Antibacterial Activity. Nanomaterials, 15(2), 84. https://doi.org/10.3390/nano15020084










